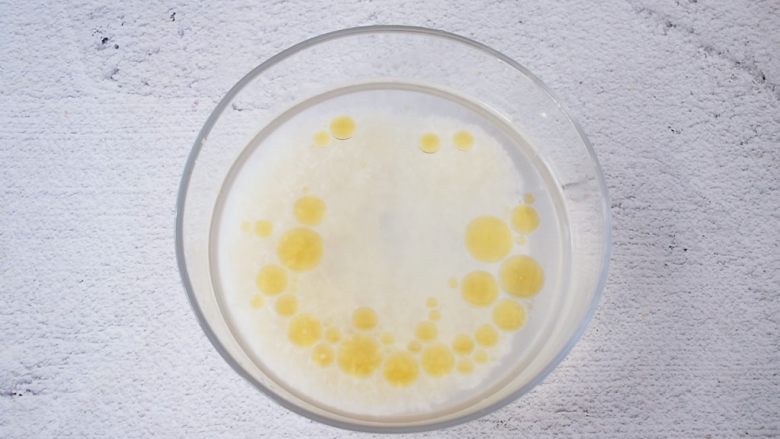

海鲜粥
今天给大家带来这碗五颜六色的海鲜粥,秋冬的早餐,最爱这1碗,暖心暖胃又鲜美,老少皆宜
995 菜谱
3335 粉丝
78 关注
食材
- 大米 150克
- 虾仁 150克
- 猪肉末 100克
- 玉米粒 20克
- 胡萝卜 20克
- 豌豆 20克
- 姜 10克
- 白胡椒粉 1勺
- 盐 适量
- 香油 1汤匙
- 料酒 1汤匙
- 纯净水 适量
步骤

1. 准备好材料

5. 把猪肉末加入适量的纯净水搅散备用

6. 把大米淘洗干净放入炖盅中,加入虾仁、玉米粒、豌豆、胡萝卜、姜丝,再倒入猪肉末水

7. 再加入适量的纯净水

8. 放入炖锅中,按三下功能键,选择煮粥功能,再按开始,然后坐等粥出锅

9. 出锅前加入白胡椒粉

10. 加入盐调味即可

11. 成品图

12. 图二
菜谱创建于:2018年11月16日 22:06